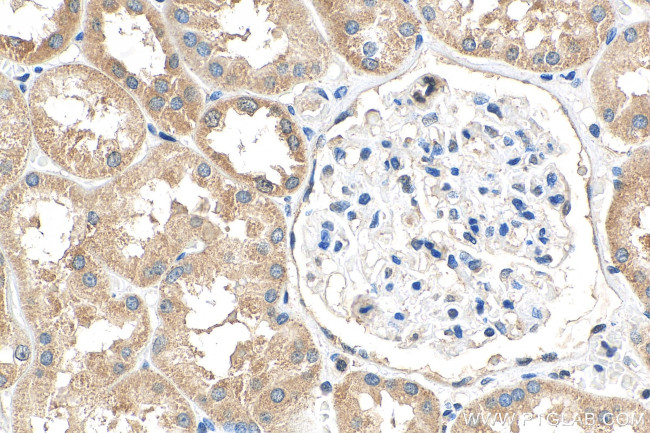
DHRS1 Antibody in Immunohistochemistry (Paraffin) (IHC (P))

Search
Proteintech
DHRS1 Polyclonal Antibody
{{$productOrderCtrl.translations['antibody.pdp.commerceCard.promotion.promotions']}}
{{$productOrderCtrl.translations['antibody.pdp.commerceCard.promotion.viewpromo']}}
{{$productOrderCtrl.translations['antibody.pdp.commerceCard.promotion.promocode']}}: {{promo.promoCode}} {{promo.promoTitle}} {{promo.promoDescription}}. {{$productOrderCtrl.translations['antibody.pdp.commerceCard.promotion.learnmore']}}
产品信息
16275-1-AP
种属反应
宿主/亚型
分类
类型
抗原
偶联物
形式
浓度
规格
纯化类型
保存液
内含物
保存条件
运输条件
产品详细信息
Immunogen sequence: MAAPMNGQV CVVTGASRGI GRGIALQLCK AGATVYITGR HLDTLRVVAQ EAQSLGGQCV PVVCDSSQES EVRSLFEQVD REQQGRLDVL VNNAYAGVQT ILNTRNKAFW ETPASMWDDI NNVGLRGHYF CSVYGARLMV PAGQGLIVVI SSPGSLQYMF NVLYGVGKAA CDKLAADCAH ELRRHGVSCV SLWPGIVQTE LLKEHMAKEE VLQDPVLKQF KSAFSSAETT ELSGKCVVAL ATDPNILSLS GKVLPSCDLA RRYGLRDVDG RPVQDYLSLS SVLSHVSGLG WLASYLPSFL RVPKWIIALY TSKF (1-313 aa encoded by BC014057)
靶标信息
This gene encodes a member of the short-chain dehydrogenases/reductases (SDR) family. The encoded enzyme contains a conserved catalytic domain and likely functions as an oxidoreductase. Multiple alternatively spliced variants, encoding the same protein, have been identified.
仅用于科研。不用于诊断过程。未经明确授权不得转售。
篇参考文献 (0)
生物信息学
蛋白别名: dehydrogenase/reductase (SDR family) member 1; Dehydrogenase/reductase SDR family member 1; DHRS1; Protein SDR19C1; Short chain dehydrogenase/reductase family 19C member 1; unnamed protein product
基因别名: 1110029G07Rik; AW112170; D14Ertd484e; DHRS1; SDR19C1
UniProt ID: (Human) Q96LJ7, (Mouse) Q99L04
Entrez Gene ID: (Human) 115817, (Mouse) 52585, (Rat) 290234